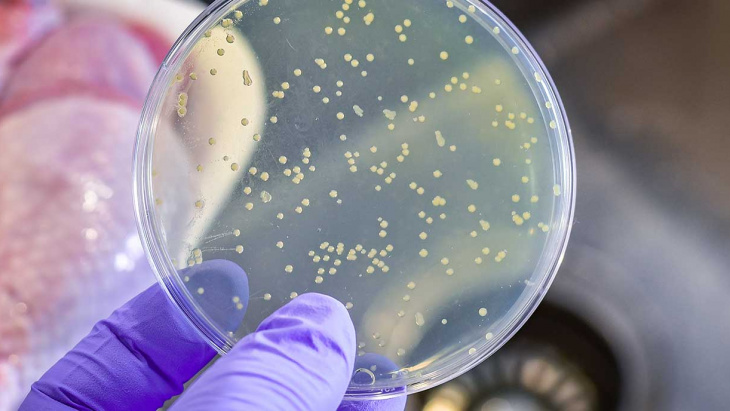
Listériose : mesures de protection insuffisantes contre les agents pathogènes

L'agent pathogène Listeria monocytogenes peut se retrouver à différentes étapes de la production d’aliments d'origine animale et végétale. Les aliments crus et les produits prêts à consommer tels que les produits laitiers, la charcuterie, les poissons fumés ou les salades prêtes à l'emploi sont le plus souvent concernés. Cet agent pathogène peut provoquer des symptômes graves, en particulier chez les personnes dont les défenses immunitaires sont affaiblies, et entraîner une fausse couche chez les femmes enceintes. En Suisse, plusieurs épidémies de listériose se sont manifestées ces dernières années, provoquant de nombreux cas de maladie voire des décès.
Deux tiers des établissements contrôlés présentent des lacunes
Afin que les produits remis aux consommateurs soient sûrs et ne présentent aucun risque pour la santé, les entreprises du secteur alimentaire doivent prendre des mesures de protection appropriées. Celles-ci comprennent, par exemple, la garantie d'une hygiène de production irréprochable ou des analyses périodiques en laboratoire des produits et de leur environnement de fabrication. Les chimistes cantonaux de Suisse et de la Principauté du Liechtenstein ont contrôlé l'application de ces mesures de protection dans 115 entreprises qui produisent des denrées présentant un risque élevé de contamination par la Listeria. Deux tiers (65%) des entreprises ne remplissaient pas les exigences du droit alimentaire, de sorte que des contestations ont dû être prononcées. Les manquements les plus fréquents concernaient l'infrastructure, l'hygiène de production ou le contrôle de l'environnement de production. Les chimistes cantonaux ont ordonné des mesures pour remédier à ces manquements. De plus, trois entreprises ont été dénoncées à l’autorité pénale.
Contrôle des denrées alimentaires en Suisse Le contrôle des denrées alimentaires et des objets usuels est effectué par les cantons, qui procèdent à des inspections et à des analyses de laboratoire approfondies. Sous la direction des chimistes cantonaux, ils veillent au respect des prescriptions légales et garantissent ainsi la sécurité des denrées alimentaires et la protection des consommateurs.
|
Communiqué de presse de l'Association des chimistes cantonaux de Suisse
